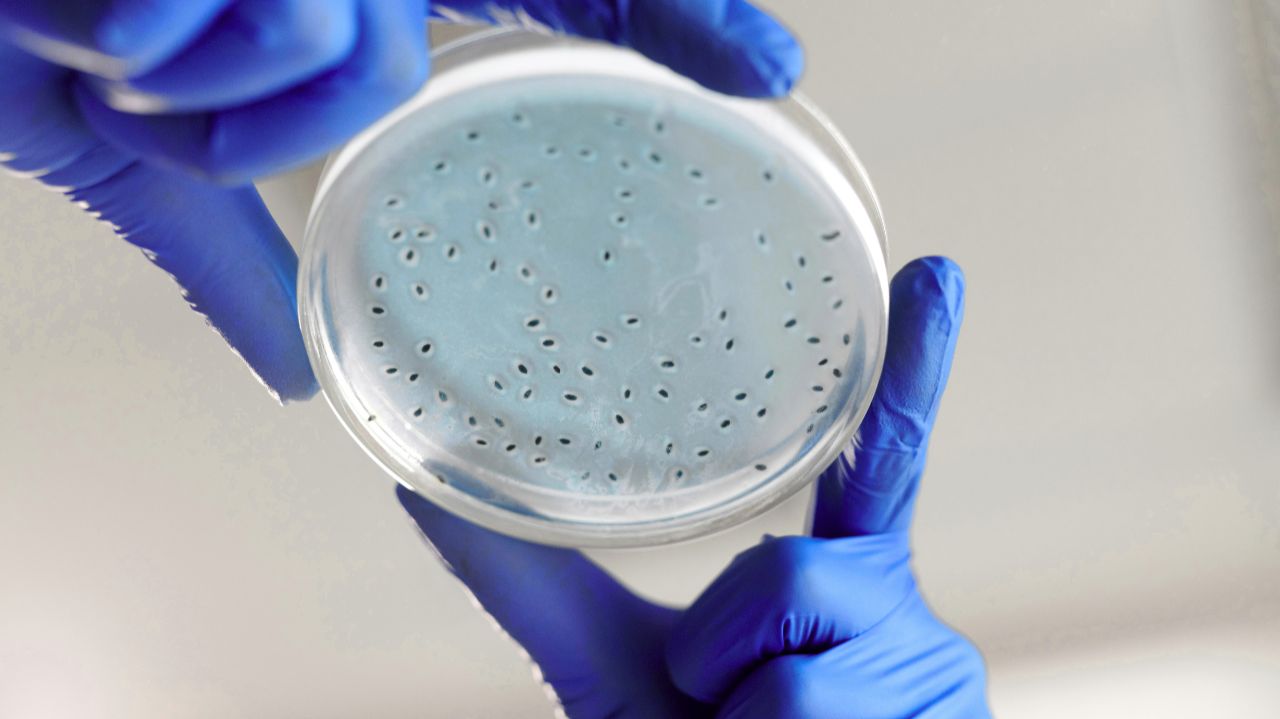
Лаборатория БИОТА

Кравченко Ю.А.

Видео
Источник: rutube.ru
⇒ Видео подборки:
Похожее видео
Комментарии ( 0
)
Сначала новые
Сначала старые
Сначала лучшие
Загружено по ссылке
⇒Расскажите об этом видео Кравченко Ю.А., своим друзьям в социальных сетях.
Ссылка на страницу с видео:
HTML-ссылка на страницу с видео:
Код для вставки плеера:Злая мама... @titwow #tiktok #мем #тикток #meme #видео #майнкрафт #...
"Классный канал, я подписался. Советую смотреть его ролики. Часто выходят стримы!"
(Добавлено: 1776479736.2052)
Подъезной путь на Кучинский керамический завод в Железнодорожном (г...
"На этих путяхя вырос сдесь стоял наш барак помню паровоз около путей была большая гора пескалюбимое место гулянкии зимой и летом у путей рядом была свалка металлолома кладезь всего нашего игрового мира это были шестидисятые года наше детство ладно пойду выпью за наш барак ваш покорный слуга ..."
(Добавлено: 1776479736.2052)
Шоу "Утро с юмором"(Фрагмент)(ВТВ, 30.11.2020) - онлайн
"Ребята, вы чудо, чудо, какие ДЕБИЛЫ вместе со своей программой. Только в Белоруси могли придумать такой идиотизм! Впрочем как и все остальное."
(Добавлено: 1776479736.2052)
CUtia neagră cu Mariana Raţă / Morari: da, m-am întâlnit cu Plahotn...
"Doamna Mariana de ce a-ti chemat la emisiune pe tâmpitul de Sergiu Sîrbu ,se uita in ochi si minte ,el vrea de dragul poporului sa se spânzure."
(Добавлено: 1776479736.2052)
Поселок Рудник, истоки Воркуты - Фото - онлайн
"Как мне кажется дорогие мои друзья, на сегодняшний достаточно много очень заброшенных мест в уголках нашей огромной страны. Вот посмотрев эти самые фотоснимки, у меня просто создается впечатления, что просто в этом поселке нет такого человека, который мог бы все это восстановить. Но все же очень ..."
(Добавлено: 1776479736.2052)
 Канал:
Канал: